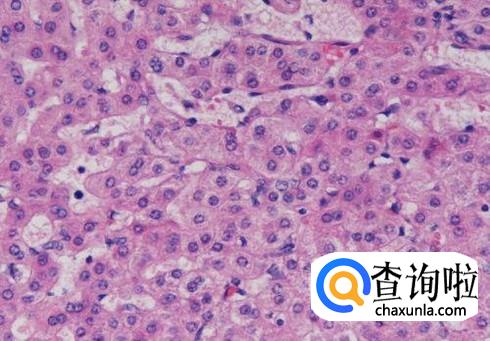

最佳回答
本文由作者推荐
工具/材料
生化检查单
详细内容
- 01
丙氨酸转移酶又称为为谷丙转氨酶,,简称为ALT,在检查单上一般都有它的简称。它是一种参与蛋白质代谢的一种生物酶,普遍存在于肝脏中,所以它的含量能够反映肝脏的疾病问题。

- 02
若是肝脏组织或细胞发生病变或坏死,都会导致血液中的谷丙转氨酶的浓度有一定程度地升高。

- 03
正常人血液中谷丙转氨酶的浓度为0-50 umol/L,超出正常值则提示肝细胞或肝脏组织受到了损伤,并存在炎症。

- 04
据研究发现,百分之一的肝细胞受损可以使血液中丙氨酸转氨酶的浓度上升一倍,因此,丙氨酸转氨酶是反映肝脏受损最灵敏的一个指标。
- 05
丙氨酸转氨酶浓度升高一般会出现食欲减退,恶心呕吐,肝区疼痛,黄疸等症状,因为肝脏是人体最大的消化腺,肝脏受损当然会出现消化系统的症状。

特别提示
丙氨酸转氨酶除了肝脏外还存在于骨骼肌、心脏等处,但是一般出现浓度升高还是会判定为肝脏受损,因此要及时治疗,以免延误病情。
广告位
点击排行
- 2 排行
- 3 排行
- 4 排行
- 5 排行
- 6 排行
- 7 排行
- 8 排行
- 9 排行
- 10 排行
热点追踪
广告位





















